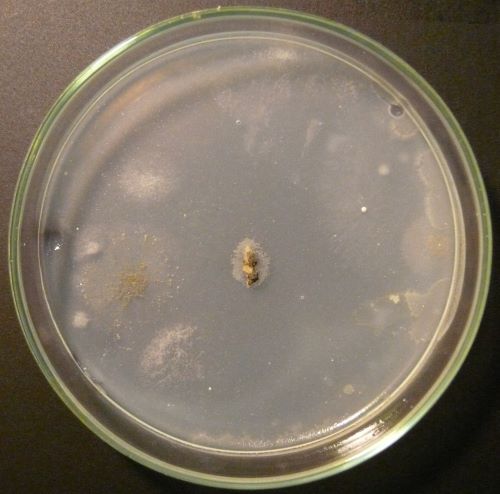

Tapetenkleister als Zuschlagstoff für Agarplatten
Moderatoren: Mycelio, leuchtpilz, davidson30
- Reblaus
- Ehren - Member
- Beiträge: 408
- Registriert: Mittwoch, 25. November 2009 22:02
- Wohnort: Wentorf bei Hamburg
- Kontaktdaten:
Tapetenkleister als Zuschlagstoff für Agarplatten
Hallo Pilzzüchter,
bei der Endjahresentrümpelung ist mir eine Tüte mit Tapetenkleister in die Hände gekommen und da musste ich zwangsläufig an meine lieben Pilzchen denken.
Folgende Idee:
Auf der Packung steht Zell-Leim. Nach Wikipedia bedeutet das, dass es sich um reine Methylzellulose handelt.
Das wäre doch ein super Zuschlagsstoff für Agarplatten.
In den meisten Agarrezepten wird als Kohlenstoffquelle Zucker oder Stärke verwendet. Wenn man stattdessen Cellulose verwendet, könnte das doch Vorteile bringen, oder?
z.B.
- weniger Degeneration des Myceles, weil die Nährstoffquelle am ehesten dem Endsubstrat entspricht und deshalb auch die selben Enzyme benötigt werden
- weniger Kontigefahr, weil die meisten Bakterien Schwierigkeiten beim Verdau von Cellulose haben
Hat das schon jemand ausgetestet bzw. was denkt Ihr?
Gruß
Reblaus
bei der Endjahresentrümpelung ist mir eine Tüte mit Tapetenkleister in die Hände gekommen und da musste ich zwangsläufig an meine lieben Pilzchen denken.
Folgende Idee:
Auf der Packung steht Zell-Leim. Nach Wikipedia bedeutet das, dass es sich um reine Methylzellulose handelt.
Das wäre doch ein super Zuschlagsstoff für Agarplatten.
In den meisten Agarrezepten wird als Kohlenstoffquelle Zucker oder Stärke verwendet. Wenn man stattdessen Cellulose verwendet, könnte das doch Vorteile bringen, oder?
z.B.
- weniger Degeneration des Myceles, weil die Nährstoffquelle am ehesten dem Endsubstrat entspricht und deshalb auch die selben Enzyme benötigt werden
- weniger Kontigefahr, weil die meisten Bakterien Schwierigkeiten beim Verdau von Cellulose haben
Hat das schon jemand ausgetestet bzw. was denkt Ihr?
Gruß
Reblaus
Zuletzt geändert von Reblaus am Mittwoch, 30. Dezember 2009 22:31, insgesamt 1-mal geändert.
- Reblaus
- Ehren - Member
- Beiträge: 408
- Registriert: Mittwoch, 25. November 2009 22:02
- Wohnort: Wentorf bei Hamburg
- Kontaktdaten:
Im Netz findet man nur Carboxy-methyl cellulose Medium (CMC).
Ein Zuschlag von 2,5 % verringert erheblich die Bildung von Kondenswasser unter verschiedensten Bedingungen. Das ist ein interessanter Aspekt.
(Quelle: http://aem.asm.org/cgi/reprint/14/1/133.pdf)
Für Tapetenkleister hilft wohl nur ein Feldversuch!
Als selektives Minimalmedium:
20 g Agar Agar / Liter
25 g Tapetenkleister / Liter
1 ml Flüssig-Volldünger / Liter (für Stickstoff, Phosphor und Spurenelemente)
0,5 g Gips / Liter
Mal sehen ob da was wächst!
Leicht wird es das Myzel bestimmt nicht haben, aber vielleicht ist ein optimiertes Rezept ganz praktikabel für das Klonieren von Wildfunden. Sobald ich wieder freie Petris habe starte ich einen Test.
Beste Grüße
Ein Zuschlag von 2,5 % verringert erheblich die Bildung von Kondenswasser unter verschiedensten Bedingungen. Das ist ein interessanter Aspekt.
(Quelle: http://aem.asm.org/cgi/reprint/14/1/133.pdf)
Für Tapetenkleister hilft wohl nur ein Feldversuch!
Als selektives Minimalmedium:
20 g Agar Agar / Liter
25 g Tapetenkleister / Liter
1 ml Flüssig-Volldünger / Liter (für Stickstoff, Phosphor und Spurenelemente)
0,5 g Gips / Liter
Mal sehen ob da was wächst!
Leicht wird es das Myzel bestimmt nicht haben, aber vielleicht ist ein optimiertes Rezept ganz praktikabel für das Klonieren von Wildfunden. Sobald ich wieder freie Petris habe starte ich einen Test.
Beste Grüße
-
- Pilzfreak
- Beiträge: 182
- Registriert: Sonntag, 25. Oktober 2009 13:38
- Wohnort: Schweiz
Andere Verdickungsmittel
Hallo reblaus
sehr interessanter Ansatz, freue mich auf Ergebnisse!
Würde aber auf jeden Fall genügend Agar beimischen, da beim Abbau der Zellulose sich das medium verflüssigen wird!
Und auch die üblichen Zutaten wie Glucose, Zucker oder Malzextrakt würde ich trotzdem beimischen. Diese Zuckerarten sind sehr einfach verwertbar, wohl für Pilz wie auch für den Menschen. Also nur Zellulose wird das Wachstum wohl erheblich bremsen.
Hab auch schon daran gedacht, Verdickungsmittel wie Carrageenane, Cellulosenderivate, Gellangummi, Xanthangummi.........
Besonders interessant wäre die Verringerung von Kondenswasser, obwohl ich da etwas skeptisch bin. Dann mal einen guten Rutsch!
Gruss Rino
sehr interessanter Ansatz, freue mich auf Ergebnisse!
Würde aber auf jeden Fall genügend Agar beimischen, da beim Abbau der Zellulose sich das medium verflüssigen wird!
Und auch die üblichen Zutaten wie Glucose, Zucker oder Malzextrakt würde ich trotzdem beimischen. Diese Zuckerarten sind sehr einfach verwertbar, wohl für Pilz wie auch für den Menschen. Also nur Zellulose wird das Wachstum wohl erheblich bremsen.
Hab auch schon daran gedacht, Verdickungsmittel wie Carrageenane, Cellulosenderivate, Gellangummi, Xanthangummi.........
Besonders interessant wäre die Verringerung von Kondenswasser, obwohl ich da etwas skeptisch bin. Dann mal einen guten Rutsch!
Gruss Rino
- Reblaus
- Ehren - Member
- Beiträge: 408
- Registriert: Mittwoch, 25. November 2009 22:02
- Wohnort: Wentorf bei Hamburg
- Kontaktdaten:
Hallo Rino,
danke für die Antwort.
Dir und natürlich auch den Anderen wünsche ich einen guten Rutsch bzw. ein gesundes neues Jahr.
Ich hatte mich gestern noch ein bisschen über meinen Tapetenkleister schlau gemacht und habe herausgefunden, dass das Zeug sehr wahrscheinlich aus reiner Natrium Carboxy-methyl-Cellulose besteht.
Beim Recherchieren, bin ich auf einen Artikel gestoßen, der sich mit der Empfindlichkeit vom Austernseitling auf Strahlung befasst . Man findet aber die folgende Tabelle, die doch sehr interessant ist.

(Quelle)
Ein bestimmter Austernstamm wurde also auf verschiedenen Medien kultiviert. Unter anderem auch auf CMC-Agar. Der Austernstamm der in diesen Versuchen verwendet wurde, wächst auf CMC-Agar genau so schnell wie auf Kartoffel-Dextrose-Agar (PDA).
Ergo ist das CMC-Medium für den Austernseitling durchaus ein Vollmedium, das ohne weitere Kohlenstoff-Supplemente auskommt. Leider ist im Artikel das Rezept für das verwendete Medium nicht dokumentiert. Ich habe aber folgendes gefunden:

(Quelle)
Ich hatte gestern zum Spaß eine 2,5 %ige Tapetenkleisterlösung gekocht.
Das hat zwar sehr geschäumt aber ansonsten gab es keine bösen Überraschungen. Die Mischung ist recht viskos.
Ich bin jedenfalls sehr gespannt. Nächstes Jahr gieße ich dann die Platten.
Allen einen guten Rutsch und beste Wünsche fürs neue Jahr!
danke für die Antwort.
Dir und natürlich auch den Anderen wünsche ich einen guten Rutsch bzw. ein gesundes neues Jahr.
Ich hatte mich gestern noch ein bisschen über meinen Tapetenkleister schlau gemacht und habe herausgefunden, dass das Zeug sehr wahrscheinlich aus reiner Natrium Carboxy-methyl-Cellulose besteht.
Beim Recherchieren, bin ich auf einen Artikel gestoßen, der sich mit der Empfindlichkeit vom Austernseitling auf Strahlung befasst . Man findet aber die folgende Tabelle, die doch sehr interessant ist.

(Quelle)
Ein bestimmter Austernstamm wurde also auf verschiedenen Medien kultiviert. Unter anderem auch auf CMC-Agar. Der Austernstamm der in diesen Versuchen verwendet wurde, wächst auf CMC-Agar genau so schnell wie auf Kartoffel-Dextrose-Agar (PDA).
Ergo ist das CMC-Medium für den Austernseitling durchaus ein Vollmedium, das ohne weitere Kohlenstoff-Supplemente auskommt. Leider ist im Artikel das Rezept für das verwendete Medium nicht dokumentiert. Ich habe aber folgendes gefunden:

(Quelle)
Ich hatte gestern zum Spaß eine 2,5 %ige Tapetenkleisterlösung gekocht.
Das hat zwar sehr geschäumt aber ansonsten gab es keine bösen Überraschungen. Die Mischung ist recht viskos.
Ich bin jedenfalls sehr gespannt. Nächstes Jahr gieße ich dann die Platten.
Allen einen guten Rutsch und beste Wünsche fürs neue Jahr!
-
- Pilzfreak
- Beiträge: 182
- Registriert: Sonntag, 25. Oktober 2009 13:38
- Wohnort: Schweiz
CMC-Medien
Hey Reblaus
ich hoffe bist gut im 2010 angekommen! Mal sehen, welche Pilzerfolge das Jahr bringt..........
Das nenn ich mal eine gründliche Recherche! Merci für die Inputs. Bin doch überrascht, dass die Mycelien dem Anschein nach vieles Verdauen, Hauptsache Kohlenstoff
Also ich bin wählerischer.
Werde bei Gelegenheit auch mal ein zwei Platten mit anderen Verdickungsmitteln giessen. Bin zwar mit Agar eingedeckt bis ins Jahr 3000
Dann freuen wir uns auf Ergebnisse, gruss
Rino
ich hoffe bist gut im 2010 angekommen! Mal sehen, welche Pilzerfolge das Jahr bringt..........
Das nenn ich mal eine gründliche Recherche! Merci für die Inputs. Bin doch überrascht, dass die Mycelien dem Anschein nach vieles Verdauen, Hauptsache Kohlenstoff

Werde bei Gelegenheit auch mal ein zwei Platten mit anderen Verdickungsmitteln giessen. Bin zwar mit Agar eingedeckt bis ins Jahr 3000

Dann freuen wir uns auf Ergebnisse, gruss
Rino
- Reblaus
- Ehren - Member
- Beiträge: 408
- Registriert: Mittwoch, 25. November 2009 22:02
- Wohnort: Wentorf bei Hamburg
- Kontaktdaten:
1. Versuch
Hi Rino,
Danke der Nachfrage, ich bin gut reingerutscht. Meine Körnerbrut leider nicht so, die war heute Morgen ganz grün
.
Ich habe den ersten CMC-Agar Versuch gestartet und fasse mal kurz zusammen.
Als erstes wurden 12,5 g Tapetenkleister in einem ¼ Liter Wasser gelöst und zum Kochen gebracht. Nachdem alle Klumpen aufgelöst waren, kamen 10 g Agar-Agar, 0,5 g Gips und 500 µl Dünger (Volldünger für Hydro) hinzu. Das hab ich dann ordentlich verrührt und auf 500 ml mit Wasser aufgefüllt und nochmals aufgekocht. Das Gemisch war zäh wie Tapetenkleister
und ist mir ein wenig angebrannt (Das sind die schwarzen Flöckchen auf dem Bild.) Mit dem Gemisch wurden dann 4 Petries bestückt. Nachdem die kalt waren, habe ich sie in Alufolie gewickelt und 30 min im Schnellkochtopf sterilisiert.
Die Deckel waren danach etwas stumpf (wahrscheinlich hat das Medium beim Autoklavieren geschäumt), deshalb habe ich sie mit 80 % Spiritus ausgewischt.
Die Petries habe ich mit 4 Stämmen beimpft.

A: Auster aus dem Bioladen
B: hoffentlich eine Krause Glucke (Im Herbst gefunden und kloniert)
C: Shiitake aus dem Bioladen
D: sollte rauchblättriger Schwefelkopf sein
Das Medium klebt übrigens kein bisschen. Es ist nur sehr hart.
Falls was wächst, werde ich beim nächsten Mal auf das Sterilisieren verzichten bzw. erst sterilisieren und dann gießen. So war es jedenfalls nicht ideal.
Bis bald
Danke der Nachfrage, ich bin gut reingerutscht. Meine Körnerbrut leider nicht so, die war heute Morgen ganz grün

Ich habe den ersten CMC-Agar Versuch gestartet und fasse mal kurz zusammen.
Als erstes wurden 12,5 g Tapetenkleister in einem ¼ Liter Wasser gelöst und zum Kochen gebracht. Nachdem alle Klumpen aufgelöst waren, kamen 10 g Agar-Agar, 0,5 g Gips und 500 µl Dünger (Volldünger für Hydro) hinzu. Das hab ich dann ordentlich verrührt und auf 500 ml mit Wasser aufgefüllt und nochmals aufgekocht. Das Gemisch war zäh wie Tapetenkleister

Die Deckel waren danach etwas stumpf (wahrscheinlich hat das Medium beim Autoklavieren geschäumt), deshalb habe ich sie mit 80 % Spiritus ausgewischt.
Die Petries habe ich mit 4 Stämmen beimpft.

A: Auster aus dem Bioladen
B: hoffentlich eine Krause Glucke (Im Herbst gefunden und kloniert)
C: Shiitake aus dem Bioladen
D: sollte rauchblättriger Schwefelkopf sein
Das Medium klebt übrigens kein bisschen. Es ist nur sehr hart.
Falls was wächst, werde ich beim nächsten Mal auf das Sterilisieren verzichten bzw. erst sterilisieren und dann gießen. So war es jedenfalls nicht ideal.
Bis bald
- Reblaus
- Ehren - Member
- Beiträge: 408
- Registriert: Mittwoch, 25. November 2009 22:02
- Wohnort: Wentorf bei Hamburg
- Kontaktdaten:
Sie wachsen!
So sehen die Platten am 9. Tag aus:

Der Shiitake wollte nicht. (Es kann sein, dass es ihm beim Umsetzen zu heiß geworden ist.) Den anderen Stämmen geht es gut. Sie wachsen langsamer als auf anderen Medien. Kontis gab es keine.
Tapetenkleister kann also als Basis für Agar-Platten verwendet werden.
Der erste Versuch war erfolgreich.
Gruß
Reblaus

Der Shiitake wollte nicht. (Es kann sein, dass es ihm beim Umsetzen zu heiß geworden ist.) Den anderen Stämmen geht es gut. Sie wachsen langsamer als auf anderen Medien. Kontis gab es keine.
Tapetenkleister kann also als Basis für Agar-Platten verwendet werden.
Der erste Versuch war erfolgreich.
Gruß
Reblaus
- Mycelio
- Site Admin
- Beiträge: 3267
- Registriert: Donnerstag, 27. September 2007 04:42
- Wohnort: Berlin-Friedrichshain
Hallo zusammen,
toller Versuch, bin begeistert!
Ich denke, daß Mehtylzellulose sich als alleinige Kohlenstoffquelle besonders für Pilze eignet, die gut Zellulose abbauen können, also alle Braunfäulepilze und wahrscheinlich viele Weißfäulepilze. Wenn dann kein Zucker und kein Hefeextrakt enthalten sind, hätten Bakterien und Hefen keine Nahrung. Bei Schimmel bin ich mir da nicht so sicher.
Grüße, Carsten
toller Versuch, bin begeistert!
Ich denke, daß Mehtylzellulose sich als alleinige Kohlenstoffquelle besonders für Pilze eignet, die gut Zellulose abbauen können, also alle Braunfäulepilze und wahrscheinlich viele Weißfäulepilze. Wenn dann kein Zucker und kein Hefeextrakt enthalten sind, hätten Bakterien und Hefen keine Nahrung. Bei Schimmel bin ich mir da nicht so sicher.
Grüße, Carsten
- Reblaus
- Ehren - Member
- Beiträge: 408
- Registriert: Mittwoch, 25. November 2009 22:02
- Wohnort: Wentorf bei Hamburg
- Kontaktdaten:
2. Versuch / Challenge mit Schimmel
Hallo Carsten,
deine Frage lässt sich leicht beantworten.
Ich hab noch einmal CMC-Agar nach dem obigen Rezept gekocht und Platten gegossen, diesmal ohne sie zu sterilisieren.
Wer Angst vor Trichoderma hat, sollte sich ab jetzt die Augen zuhalten
.
Ich habe im Keller (im hintersten Winkel) noch einen Eimer mit verseuchtem Substrat stehen (sollte Rauchblättriger Schwefelkopf sein). Jetzt ist er doch noch für etwas nützlich
.


Nach dem was ich bis jetzt gelesen habe, sollte leider auch Schimmel auf den Platten wachsen. Vor Hefen und den meisten Bakterien sollten sie aber sicher sein.
Update folgt.
deine Frage lässt sich leicht beantworten.
Ich hab noch einmal CMC-Agar nach dem obigen Rezept gekocht und Platten gegossen, diesmal ohne sie zu sterilisieren.
Wer Angst vor Trichoderma hat, sollte sich ab jetzt die Augen zuhalten

Ich habe im Keller (im hintersten Winkel) noch einen Eimer mit verseuchtem Substrat stehen (sollte Rauchblättriger Schwefelkopf sein). Jetzt ist er doch noch für etwas nützlich



Nach dem was ich bis jetzt gelesen habe, sollte leider auch Schimmel auf den Platten wachsen. Vor Hefen und den meisten Bakterien sollten sie aber sicher sein.
Update folgt.
- Mycelio
- Site Admin
- Beiträge: 3267
- Registriert: Donnerstag, 27. September 2007 04:42
- Wohnort: Berlin-Friedrichshain
Re: Tapetenkleister als Zuschlagstoff für Agarplatten
Ja, man sollte immer einen Eimer mit Trichoderma im Keller haben...
Der ist aber auch ein Prachtexemplar. Falls du im Sommer Tomaten züchtest, kannst du den in die Erde mischen und damit Kraut- und Braunfäule unterdrücken.
Aber zurück zum Thema. Ich würde auch vermuten, daß der Grünschimmel auf CMC gut wächst, denn einerseits kann er Holz zersetzen, da wird die Zellulose kein Hindernis darstellen. Andererseits ist Trichoderma ein Bodenbewohner und kann dann bestimmt auch die Salze aus dem Dünger verwerten. Aber schauen wir mal, was passiert.
Grüße, Carsten

Aber zurück zum Thema. Ich würde auch vermuten, daß der Grünschimmel auf CMC gut wächst, denn einerseits kann er Holz zersetzen, da wird die Zellulose kein Hindernis darstellen. Andererseits ist Trichoderma ein Bodenbewohner und kann dann bestimmt auch die Salze aus dem Dünger verwerten. Aber schauen wir mal, was passiert.
Grüße, Carsten
- Jinx
- Ehren - Member
- Beiträge: 229
- Registriert: Freitag, 06. Oktober 2006 21:10
- Wohnort: "Middlfrangn"
Re: Tapetenkleister als Zuschlagstoff für Agarplatten
Hehehe... Der Eimer sieht aus wie ein uralter französischäää Schimmelkäse...
@Mycelio: Funktioniert das wirklich gegen die Braunfäule oder ist das jetzt nur ein theoretisches Gedankenkonstrukt von dir? Das Schimmel antibiotisch wirkt is klar aber in solchen Mengen? Nicht das das dann antitomatisch wirkt?
@Mycelio: Funktioniert das wirklich gegen die Braunfäule oder ist das jetzt nur ein theoretisches Gedankenkonstrukt von dir? Das Schimmel antibiotisch wirkt is klar aber in solchen Mengen? Nicht das das dann antitomatisch wirkt?

- Mycelio
- Site Admin
- Beiträge: 3267
- Registriert: Donnerstag, 27. September 2007 04:42
- Wohnort: Berlin-Friedrichshain
Re: Tapetenkleister als Zuschlagstoff für Agarplatten
Nö, die Schimmelpilze, die uns das Leben schwer machen, sind des Gärtners bester Freund. Sie wachsen ja normalerweise in der Erde und gehören zum gesunden Bodenleben. Inzwischen gibt es eine ganze Menge von Präparaten, die die Sporen von Trichoderma und anderen enthalten.
Viele der pflanzenschädliche Pilze leben erst im Boden und infizieren die Pflanzen über die Wurzeln. Sind aber Schimmelpilze in ausreichender Zahl vorhanden, können sich die bösen gar nicht erst ausbreiten oder sterben ab. Antibiotische Stoffe werden dabei bestimmt eine Rolle spielen, Trichoderma ist aber auch dafür bekannt, andere Pilzmycelien zu parasitieren.
Grüße, Carsten
Viele der pflanzenschädliche Pilze leben erst im Boden und infizieren die Pflanzen über die Wurzeln. Sind aber Schimmelpilze in ausreichender Zahl vorhanden, können sich die bösen gar nicht erst ausbreiten oder sterben ab. Antibiotische Stoffe werden dabei bestimmt eine Rolle spielen, Trichoderma ist aber auch dafür bekannt, andere Pilzmycelien zu parasitieren.
Grüße, Carsten
- Reblaus
- Ehren - Member
- Beiträge: 408
- Registriert: Mittwoch, 25. November 2009 22:02
- Wohnort: Wentorf bei Hamburg
- Kontaktdaten:
Update
Nach einen knappen Monat sieht die Platte so aus.

Fazit: Schimmel wächst, aber langsam.
Drei weitere Platten wurden mit Auster, Glucke und Schwefelkopf (von den oben gezeigten Petris) beimpft. Sie sind nicht nennenswert gewachsen. Ich vermute, dass die ersten Platten so vielversprechend aussahen, weil noch genügend Nährstoffe im Impfstück waren.
Vielleicht ist der pH-Wert kritisch. Ich werde das bei Gelegenheit prüfen.
Den Eimer hab ich übrigens entsorgt. Der Stamm ist nun für immer verloren
.
Fazit: Schimmel wächst, aber langsam.
Drei weitere Platten wurden mit Auster, Glucke und Schwefelkopf (von den oben gezeigten Petris) beimpft. Sie sind nicht nennenswert gewachsen. Ich vermute, dass die ersten Platten so vielversprechend aussahen, weil noch genügend Nährstoffe im Impfstück waren.
Vielleicht ist der pH-Wert kritisch. Ich werde das bei Gelegenheit prüfen.
Den Eimer hab ich übrigens entsorgt. Der Stamm ist nun für immer verloren
